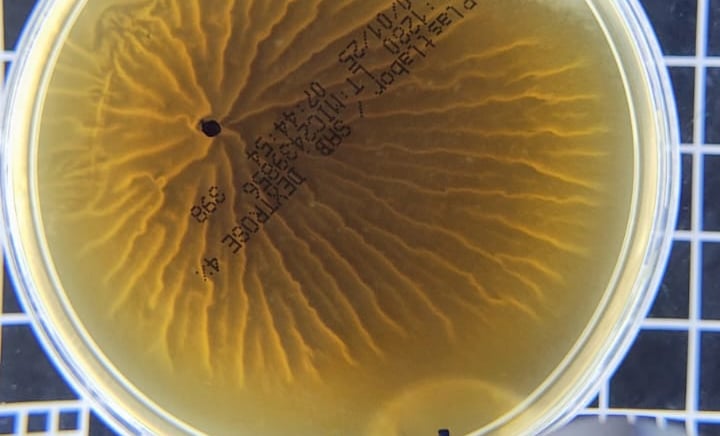
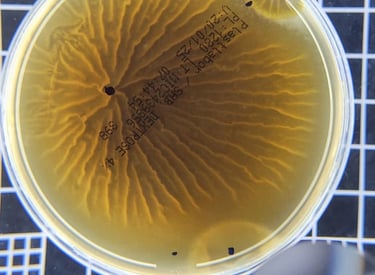
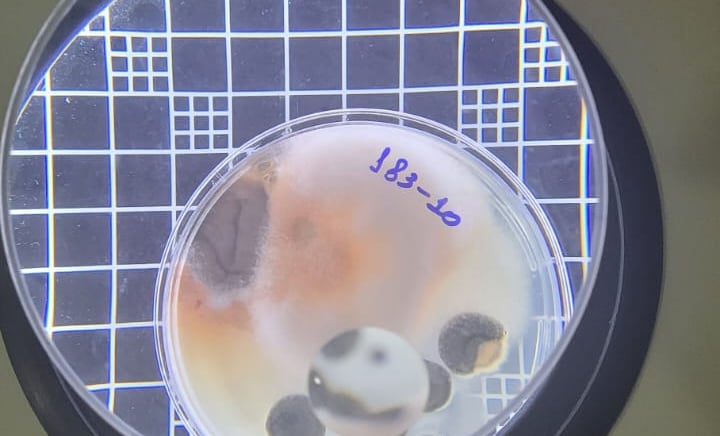
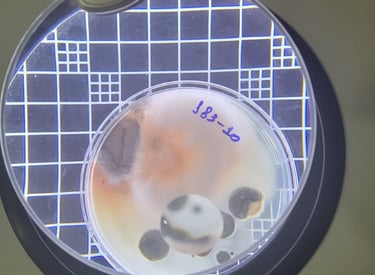

Excelência em Análises de Laboratório e Soluções Ambientais
Garantimos a segurança e a qualidade do ar e da água que você precisa.
Análise de Legionella
Detecção e prevenção
Avaliação e controle ambiental
Testes químicos e microbiológicos.
Qualidade do Ar Interior
Potabilidade da Água
Testes de água segura.
Análises de Laboratório
Sobre Nós
No Laboratório Amb, oferecemos análises químicas e biológicas com excelência, focando na qualidade e eficiência para garantir resultados confiáveis aos nossos clientes.Somos uma empresa nacional com ampla experiência no setor de análises de laboratório, qualidade do ar interior, legionella e potabilidade.
Nossa equipe altamente qualificada e dedicada está comprometida em fornecer serviços de excelência para garantir a segurança, saúde e a qualidade dos ambientes internos.




Nossa Missão
Nossa missão é fornecer análises de laboratório precisas e serviços especializados em qualidade do ar interior, visando garantir ambientes mais saudáveis e seguros.




Nossos Serviços
Análises químicas e biológicas com excelência e eficiência para garantir a qualidade dos resultados.
Análise de Legionella
Realizamos análises de Legionella para garantir a segurança da água em ambientes climatizados.

Qualidade do Ar
Oferecemos serviços de análise da qualidade do ar interior, assegurando ambientes saudáveis e seguros.

Legionella em sistemas de condicionamento de ar
A legionella pneumophila é a bactéria responsável pela doença do legionário, que pode afetar gravemente o sistema respiratório. Ela é especialmente perigosa em ambientes onde possa ocorrer a pulverização de água, como em bandejas coletoras de água de sistemas de ar-condicionado e torres de arrefecimento.
A AMB realiza análises para pesquisa de legionella em águas de bandejas coletoras com base na NBR ISO 11731:98.
A qualidade das análises do Laboratório Amb superou minhas expectativas. Recomendo a todos os meus colegas.
João Silva
Serviço excelente e rápido. Fiquei muito satisfeito com a análise da potabilidade da água realizada.
Maria Costa
★★★★★
★★★★★
Links Rápidos
Conecte-se conosco
Contato








